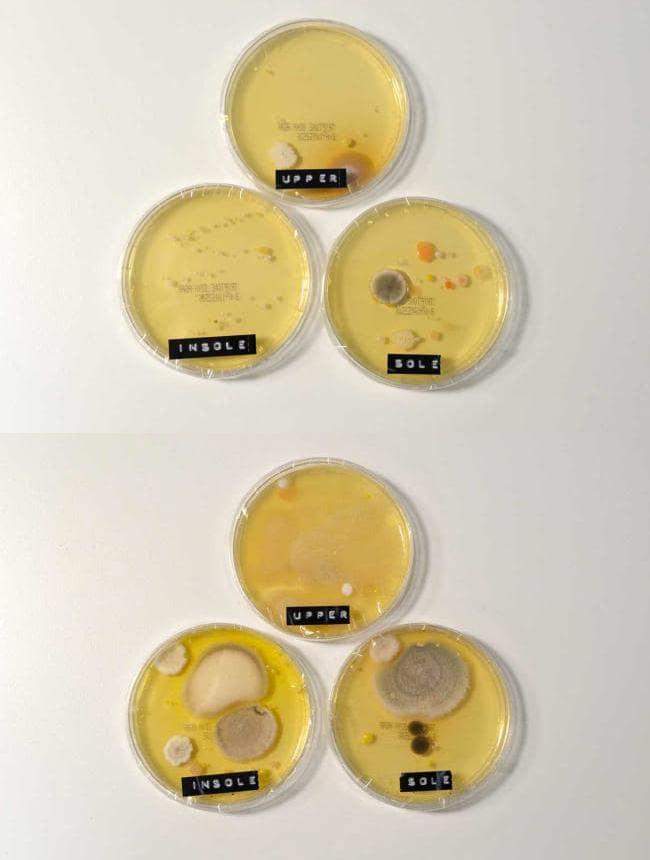
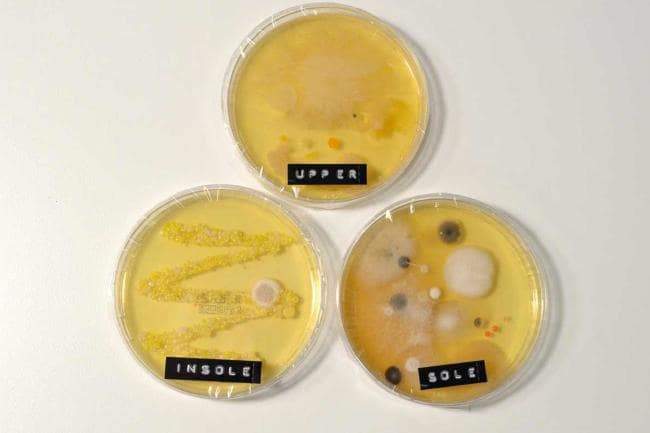

Что будет если носить кеды без носков
Можно ли носить кеды без носков: модные тенденции и стильные образы
“Нас встречают по одежке, только по одёжке судят нас” пелось когда-то в шутливой немецкой песенке. Но время летит вперед, обычаи меняются, и вот уже модников судят еще и по обувке. Не удивительно, что стильные красавицы заинтересованы в своей обуви и так тщательно следят за сменой обувных новинок. Ведь она должна быть не только удобной, но еще и модной. А с наступлением теплого времени года у многих возникает вопрос: можно ли носить кеды без носков? Будет ли это стильно и удобно? И вообще, как носить кеды в этом году? Эта статья разберет не только фэшн-стороны этого вопроса, но и рекомендации врачей.
Мода из прошлого года
Не всякий фасон обуви вообще допускает ношение носков. Но на подиумах России новация “кеды на босую ногу” впервые появилась в не таком уж и далёком две тысячи пятнадцатом году. Однако пришедшая из солнечной Италии новинка не была оценена по достоинству. И только весной прошлого года на улицах все чаще стали проводиться смелые эксперименты: молодые люди, а потом уже и девушки, снова и снова надевали на голую ногу кроссовки, мокасины и другую привычную обувь. Но “лидером ношения” стали кеды. Так можно ли идти на поводу у спонтанно поднявшейся модной волны? И как же носить кеды: с носками, или без?
Носят ли кеды без носков?
Кеды можно и даже нужно носить без носков. Действительно, модный “без носочный” лук все набирает популярность на улицах и среди девушек, и среди юношей. Особенно он выгоден красавицам со стройными щиколотками. Кроме того, отсутствие полоски носка визуально уменьшает обхват ножки и будто бы удлиняет её. Так же это выглядит по-летнему тепло и нарядно, будто бы воздушно. Так что без носков кеды носить можно и даже нужно, так как нередко из-за недостатка воздуха летом ноги, стянутые носками, начинают болеть, а кожа на них портиться. Но и здесь не без сложностей…
Что может пойти не так?
Увы, нередко увлекательные эксперименты превращаются в настоящее мучение. Непродуманный поход в даже самых удобных кедах, надетых на босую ногу, грозит моднице болезненными ощущениями, натоптышами, опухолями и даже неприятным запахом, который наверняка въестся в материал обуви… Да, список пугающе длинен.
Пара простых вещей, которые нужно сделать прежде, чем смело выходить на улицу:
Модные тренды
В этом году все большую популярность набирают яркие, стильные и в какой-то мере даже безумные модели. Кардинально меняются не только фасоны кед, но и ткани, из которых они изготовляются. Уместны вставки из легких, тонких и даже кружевных материй.

Множество моделей с самым разнообразным рисунком обрадуют любую модницу. Здесь и дерзкие цветовые сочетания, и сочные оттенки, и пастельная нежность, и скромная простота…


Поклонницы традиционных кед так же не останутся без пары-другой свежих моделей.
Привычный нам фасон часто теперь украшен декоративными ремешками, бусинами, подвесками, молниями и нашивками.

Особой популярностью пользуются кеды белого, нежно-розового и голубого цветов.

Как итог, в этом году самые разнообразные кеды занимают почетное место в гардеробе любой модницы. Ведь их можно сочетать практически с любой одеждой. А носить эту удобную обувь можно как с носками, так и без!

Страшные последствия ношения кроссовок без носков
Некоторым людям нравится носить кроссовки без носков. Они думают, что от этого ноги чувствуют себя более свободно, дышат, и носок совсем не мешает. Но люди не знают, что такая привычка вредна для человека. И если сейчас кажется все в порядке, негативные последствия рано или поздно проявят себя.
Без носков ноги плохо пахнут
Многим кажется, что в кроссовках у них ноги остаются чистыми. Но за день в этой части тела выделяется до 500 мл пота. По объему это примерно одна бутылка воды или сладкого напитка. Это довольно много жидкости!
Если бы пот был стерильной жидкостью, то такое количество влаги в кроссовках все равно действовало бы негативно на ноги. К сожалению, в поте живут бактерии. Они быстро размножаются во влажной и темной среде. И ваши чистые ноги, которыми вы гордились, будут отвратительно пахнуть, если вы не наденете носки.
Негативных последствий может быть больше, чем вы себе представляете
Ношение обуви без носков может негативно сказаться на вашем здоровье. Многие кроссовки не предназначены для прямого контакта с кожей. Поэтому в течение дня на ней могут образовываться мозоли.
Водянки на ногах болезненны. Но если у вас нет носка, вы делаете открытую рану доступной для среды, которая кишит бактериями. Через мозоль они спокойно попадают в кровеносную систему, инфицируя организм. Иногда последствия этого необдуманного действия могут привести и к летальному исходу.
Также носки выступают барьером для грибковых инфекций, которые также любят влажную, теплую и темную среду. Вы даже не заметите, как в один момент на ногах появятся характерные симптомы различных микозов.
Для охлаждения организма он выделяет пот, который должен испаряться достаточно быстро. Закрытые кроссовки препятствуют этому процессу. Поэтому необходимо придерживаться основных методов профилактики: чередовать обувь, проветривать ее, сушить, обрабатывать специальными средствами, использовать ортопедические стельки.
Почему люди не носят носки, когда это нужно?
В холодное время года теплые носки находятся на вершине списка необходимых предметов. Поэтому для многих сложилась стойкая ассоциация тепла с этими предметами гардероба. По этой причине летом они отказываются от ношения носков.
Но стоит отметить, что зимний аксессуар существенно отличается от спортивного его варианта. Последний призван впитывать лишнюю влагу и поддерживать гигиену в обуви летом.
Также многим людям не нравится, как выглядят носки, когда они выглядывают из обуви. Во многих ситуациях это кажется неуместным. Но ведь всегда можно обыграть стиль с помощью забавных рисунков и узоров на этой детали одежды. Если же вам совсем не хочется показывать носки из обуви, всегда можно найти укороченный вариант. Такие носки не будут выглядывать за пределы кроссовок, от чего получится создать впечатление, будто вы вообще забыли их надеть.
Есть еще одна категория людей, которые просто забывают или не успевают по утрам надевать носки. Но ведь можно заранее закинуть их в сумку и использовать в любой свободный момент, чтобы не травмировать свои ноги.
Пришло время начать всегда носить носки
Из информации выше понятно, почему всегда нужно носить носки. Если же это не стало вашей привычкой, вот несколько советов, как ее получить:
Незначительные вещи могут иметь большое значение в жизни
Выйти из дома без носков кажется таким незначительным поступком, но он может иметь драматическое влияние на вашу жизнь. По крайней мере, вы будете замечать людей, убегающих от зловония, каждый раз, когда вы снимаете обувь. В худшем случае вы можете столкнуться с опасной для жизни инфекцией.
Ваши ноги поддерживают вас весь день. Позаботьтесь о них, защитив их красивыми носками.
Почему не стоит носить кроссовки без носков: шокирующее исследование
Летом так и хочется отказаться от носков. Но ученые настойчиво не рекомендуют этого делать. Исследование показало, что такая привычка может стать причиной размножения бактерий и даже грибка.
Ученые провели исследование, чтобы проверить, стоит ли носить обувь без носков. Для этого они взяли мазки с поверхности обуви, подошвы и стельки. Затем их поместили в чашки Петри, в которых в течение 5 дней в лабораторных условиях могли бактерии «расти». Результаты впечатляют!
Кроссовки из ткани
Первое испытание проводилось на тканевой обуви. И очень не зря, ведь такие модели как Converse Low Tops, желательно носить без носков.
Фотосравнение, тканевые кроссовки с носками и без носков:
Кожаные кроссовки
По общему признанию, кожаные кроссовки редко носят без носков. Но это не мешает исследователям проверить, насколько активно там могут размножаться бактерии. Без носков, как и ожидалось, их количество было значительно больше. Особенно интересно: во время теста исследовали как белые, так и черные Nike Air Force 1.
Фотосравнение, кожаные кроссовки с носками и без носков:
Спортивные кроссовки против повседневной обуви
Для третьего теста выбрали кроссовки, которые носили в тренажерном зале, а также обычные кроссовки для повседневной носки. Сюрприз: в кроссовках значительно меньше бактерий, чем ожидалось.
В спортивных кроссовках бактерии размножаются не так активно:
И теперь дважды, а то и трижды подумай перед тем, как носить обувь без носков. Как показывают исследования, ничего хорошего из этого не будет!
8 пар мужской обуви, которую можно носить без носков
Мужские сандалии с носками уже давно стали поводом для шуток и анекдотов. Но это было бы весело, если бы не было так грустно. С наступлением летнего сезона вопросы о том, что можно обувать на голую ногу, а что – нет, становятся актуальными.
Тенденция sockless («без носка») покорила мир моды и довольно быстро вышла на улицы. Без носков сегодня носят много видов мужской обуви, начиная открытыми сланцами и заканчивая дерби, которые по форме близки к туфлям. Ношение последних на босую ногу приветствуется правилами стиля, но вызывает недоумение у консерваторов. Предлагаем вам гид по мужской обуви, часть из которой допустимо носить без носков, а часть – строго обязательно.
Как отказаться от носков
Мужчины в меньшей степени по сравнению с женщинами готовы жертвовать своим комфортом ради образа. В ответ на упреки о сандалиях на носки и прочем подобном они приводят множество причин в пользу того, почему они это делают и собираются продолжать. Предлагаем альтернативные решения самых распространенных проблем, связанных с отказом от носков.
→ Если обувь натирает, нужно купить другую, или заклеить проблемное место лейкопластырем, например, надежным Compeed. Размягчить края и быстрее разносить обувь поможет специальная растяжка.
→ В гигиенических целях можно использовать дезодорант для обуви или тальк для ног.
→ Если вам холодно, выбирайте закрытую обувь, которую можно носить с носками, а не пытайтесь утеплить открытую носками.
→ Считаете, что ступни не самая привлекательная часть мужского тела? Наличие гигиенического педикюра «социализирует» ваши ноги, но если открывать их вам все равно не хочется, то выбирайте комфортную для себя закрытую обувь.
8 видов обуви, которую носят без носков
№1. Сандалии
Этой обуви уже больше пяти тысяч лет, ее носили древние греки и римляне. Им бы даже в голову не пришло надеть открытые сандалии с носками (даже если представить, что они были в их гардеробе). Сандалии придуманы специально для жаркой погоды, поэтому босые ноги – единственное логичное и уместное сочетание.
Идеальная компания для сандалий – льняные летние брюки, чиносы и шорты. При этом длинные брюки можно небрежно подворачивать до уровня щиколотки.
Правило: строго без носков.
№2. Шлепки и вьетнамки
Исключительно пляжная обувь, само строение которой не позволяет носить ее с носками. По правилам стиля пляжную обувь не носят ни с джинсами, ни с брюками, ни с какой другой городской одеждой. Максимум для сланцев и вьетнамок – пляжные шорты.
Правило: строго без носков.
№3. Мокасины
Это мягкая кожаная обувь придумана индейцами, она была легкой, гибкой и позволяла бесшумно передвигаться. Сегодня настоящие мокасины по-прежнему шьются из мягкой кожи или замши, которая словно оборачивает стопу коконом. Носят мокасины без носков по двум причинам: они открытые сверху – раз, и они летние – два. Хорошо смотрятся сочетания мокасин как с обычными брюками, так и с укороченными, открывающими щиколотки, а также с шортами.
Допускается носить мокасины с носками, но только в том случае, когда они будут скрыты брюками, или с носками-следками. Табу распространяется на трио мокасины-носки-шорты.
Правило: носки допустимы, если будут скрыты длиной брюк. Строго без носков в сочетании мокасины + шорты.
№4. Топсайдеры
Название произошло от английского «topside» – верхняя палуба. Топсайдеры – морская вариация на тему мокасин, к которым добавили шнуровку вокруг пятки и рифленую подошву. Изобрели эту обувь специально для яхтсменов: за счет кожаного шнурка вокруг пятки она лучше держалась на ноге, а рифленая подошва не позволяла скользить по мокрой палубе.
Топсайдеры носят строго без носков, а лучше – с подвернутыми брюками, придающими образу элегантную небрежность.
Правило: строго без носков.
№5. Эспадрильи
Тканевая обувь на плетеной джутовой подошве популярна как никогда. Легкая, не натирающая, дышащая обувь незаменима в жару в комплекте с шортами, бриджами, льняными брюками, чиносами и джинсами. Этой паре точно не требуется дополнение в виде носков, ее носят исключительно на голую ногу.
Эспадрильи были изобретены испанскими крестьянами, но позже полюбились людям высшего сословия за ее легкость, комфортность и универсальность. Эспадрильи были в гардеробе Эрнеста Хемингуэя, Пабло Пикассо, Сальвадора Дали и Джона Кеннеди. Согласитесь, достойная компания!
Правило: строго без носков.
№6. Низкие кеды
Тенденция ношения обуви без носков захватила и спортивную обувь. Понятно, что беговые кроссовки или высокие кеды носить без носков нелогично и негигиенично, но вот сочетание летних брюк или шорт с низкими кедами позволяет отказаться от носков. Если вы не хотите изменять традициям, выберите пару хлопковых следков или низких носков специально для ношения с летней одеждой.
Правило: допустимы короткие носки и следки, но можно и без них.
№7. Лоферы
Существует несколько разновидностей лоферов, которые отличаются фирменными деталями и собственной историей. Самые распространенные виды – пенни-лоферы, лоферы с кисточкой, с пряжкой, с бахромой, венецианские и слиперы, – и у каждого есть свои нюансы в отношениях с носками. Общему правилу подчиняются только комплекты из лоферов и формального костюма: в таком сочетании носки обязательны. Лоферы носят без носков в сочетании с неформальными костюмами и casual одеждой. Идеальны укороченные брюки в комплекте с футболкой и пиджаком.
Правило: строго без носков носят слиперы. Допустимо, но необязательно ношение носков для пенни-лоферов, моделей с пряжкой, кисточками, бахромой и венецианских лоферов.
№8. Дерби
Дерби – это менее формальная разновидность оксфордов, то есть туфель на шнуровке, подошве и классическом каблуке. Отличие дерби от оксфордов в расположении шнуровки: в дерби она открытая, в оксфордах – закрытая. Наглядно это продемонстрировать очень легко: расшнуруйте ботинки и проведите пальцем от начала язычка до носа ботинка. Если деталь с дырками для шнурования составляет единое целое с ботинком, то это дерби. Если же боковые шнуровочные детали жестко вшиты поперечным швом, то это оксфорды.
Оксфорды не носят без носков, дерби – носят. Их летний вариант может быть еще более неформальным за счет яркой цветной подошвы. Скажем, темно-синие дерби на желтой подошве будут прекрасно смотреться на босой ноге с подвернутыми или укороченными джинсами.
Правило: допустимо ношение как без носков, так и с носками.
«Опасно ли носить обувь без носков?» Редакция The Village продолжает с помощью экспертов отвечать на самые странные вопросы о жизни, которыми задаются горожане
Московские модники предпочитают даже в самую жару щеголять по городу в кроссовках и кедах на босу ногу. А не вредит ли это ногам? Мы обратились к врачу-дерматологу Андрею Фёдорову и узнали, стоит ли изменять сандалиям с кроссовками и чем могут обернуться прогулки по городу босиком.
Андрей Фёдоров
Можно ли ходить по улицам босиком? На самом деле, главная опасность кроется в механических повреждениях. Есть опасность поранить ногу камушком или стеклом, туда попадёт инфекция — и начнётся заражение. Без раны никакую заразу ноге подцепить не получится. Улица — это не то место, где гуляет грибок. Им можно заразиться только в бассейне, бане, душевых, на деревянных пляжах и других общественных пространствах, где люди обычно ходят босиком.
Самый кошмар, на самом деле, кроется в другом — в ношении кроссовок, туфель, кед на босу ногу. Кожа в такой обуви (даже если она из ткани, как Converse, например) совершенно не дышит. Это чревато тремя большими проблемами. Первое — это обострение грибка. Часто бывает, что он есть, но на начальной стадии и поэтому совершенно незаметен. В кроссовках для него создаются тепличные условия. Вторая проблема — это мозоли: нога потеет и постоянно трётся об обувь. Ничего страшного, но и приятного мало. Третья — это раздражение от избытка жидкости на коже, типа потницы. Они происходят от того, что кожа не может впитать или выветрить выделившийся пот, от этого появляются покраснения.
Оптимальный вариант в жару — носить сандалии или босоножки. Максимум, что вам грозит, — это мозоли от ремешков.